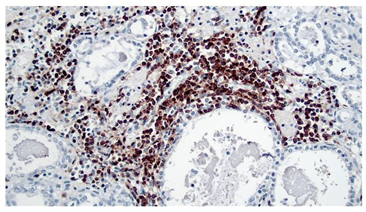

Introducción
El hipotiroidismo es el trastorno endocrino más común en caninos (1,2,3; el desorden se define como la acción deficiente de hormonas tiroideas sobre los órganos blanco como consecuencia de una inadecuada secreción de T4 y T3, defectos en receptores nucleares (resistencia a la hormona) o defectos secretorios o moleculares de la tirotropina u hormona estimulante de la tiroides (TSH) 4. La mayoría de los casos se observan en perros de más de un año de edad, aunque un 10% puede corresponder a animales más jóvenes. Alrededor del 3% de los casos son congénitos, mientras que el resto se refiere a la patología adquirida durante el crecimiento 4. Cerca del 95% de los casos en adultos corresponden a un desorden primario de la glándula tiroides, mientras que un 5% o menos es debido a deficiencia de TSH (pituitaria o hipotalámica) 5.
Ciertas razas: Golden Retriever, Labrador Retriever, Doberman Pinscher, Dachshund, Bóxer, Bulldog, Gran Danés, entre otras se reportan como las más afectadas 2,6,7. No se conoce el mecanismo exacto del desorden, aunque se sugiere un patrón poligénico de herencia similar al descrito en el humano 7. La raza Pastor Alemán y la mestiza se consideran como de bajo riesgo 6.
El hipotiroidismo canino se clasifica según su origen en primario (tiroideo), secundario (pituitario) y terciario (hipotalámico) 8. En el hipotiroidismo primario existe una reducción del tejido tiroideo funcional a través de dos mecanismos: El primero se debe a una tiroiditis linfocítica, la cual es la causa de aproximadamente la mitad de los casos de hipotiroidismo primario 9,10; al 60% de estos le subyace un desorden autoinmune 4. El segundo mecanismo es la atrofia idiopática, en la cual existe una degeneración y exfoliación de las células epiteliales hacia el coloide y el parénquima se reemplaza por tejido adiposo o fibroso 10,11. Otras causas menos comunes de hipotiroidismo primario incluyen la destrucción de la glándula por tumores no funcionales de la tiroides, por la invasión de otros tumores, por medicamentos, tratamiento quirúrgico o con yodo radioactivo; o por causas congénitas las que incluyen deficiencia en la toma de yodo dietario, hormonogénesis defectuosa, o hipoplasia, aplasia y disgenesia tiroidea 3. El hipotiroidismo secundario se debe a una disminución de la secreción de TSH por parte de la hipófisis y se asocia generalmente con malformaciones o neoplasias pituitarias 8. El hipotiroidismo terciario se define como una deficiencia en la secreción de hormona liberadora de tirotropina (TRH) desde los núcleos supraóptico y paraventricular del hipotálamo, la carencia de esta hormona causa deficiencia de TSH y atrofia folicular de la glándula tiroides 3,12.
Los feocromocitomas son los tumores más comunes que se pueden observar en la médula adrenal; siendo el canino la especie más afectada entre los animales domésticos, en estas se observa como se subdivide la médula en pequeños lóbulos separados por tejido conectivo, en los cuales se observa un incremento en el número de células que varían de cuboidea a poliédricas de diferentes tamaños, con núcleos hipercromáticos 13,14. Pueden tener actividad secretora principalmente de norepinefrina y en casos de malignidad suelen invadir la vena cava caudal y hacer metástasis comúnmente hacia hígado 13.
En el presente artículo se describe un caso de hipotiroidismo primario en un canino con sus efectos sistémicos y en concomitancia con un feocromocitoma.
Descripción de caso
Anamnesis y hallazgos clínicos
A la Clínica para Pequeños Animales de la Universidad Nacional de Colombia sede Bogotá ingresó una hembra canina, raza labrador de 6 años de edad y 38 kg de peso con anamnesis de síncopes esporádicos, alopecia en la región nasal y de la cola, episodios de disnea y disminución de la actividad física. Clínicamente se encontró depresión leve; alopecia, descamación, hiperpigmentación e hiperqueratosis en piel de la cola y nariz; descamación severa en región cervical, torácica, abdominal, periocular y en miembros posteriores; a la auscultación de evidenciaron sonidos cardiacos hipofonéticos. Paraclínicamente, se encontró alteración del perfil de hormonas tiroideas, hiperlipidemia y aumento de la fosfatasa alcalina (la primera muestra de suero fue lipémica) (Tabla 1).
Tabla 1 Valores paraclínicos hallados en el paciente. TSH: Hormona Estimulante de la Tiroides, TT4: Tetrayodotironina Total, FA: Fosfatasa Alcalina.
Al examen electrocardiográfico se evidenció taquicardia supraventricular. El animal fue tratado con Levotiroxina 0,22 mg/kg, BID; Carvedilol 0,3 mg/kg, BID; Enalapril 0,3 mg/kg, BID; Cefalexina 20 mg/kg, TID. Tras 5 meses de poca evolución clínica, con solo recuperación parcial de le densidad del pelo y un periodo de hospitalización por severa taquicardia, inapetencia y síncopes, el paciente fallece súbitamente.
Resultados
Hallazgos a la necropsia
Condición corporal 4/5; membranas mucosas orales cianóticas y conjuntival palidez severa; piel con moderada reducción de la densidad del pelo en la región abdominal ventral y descamación en la región facial. Glándulas tiroides disminución de tamaño severo, contornos irregulares con reemplazo por tejido graso (Figura 1).

Figura 1 Glándula tiroides: severamente isminuida de tamaño, superficie irregular e infiltración adiposa.
La médula adrenal derecha tenía una masa redondeada de 1,2 x 0,9 cm de coloración amarilla y superficie irregular que se expandía hacia la corteza (Figura 2). La vasculatura coronaria arterial era prominente de forma severa, con superficie irregular, material granular blanco amarillento intramural y oclusión luminal parcial, además había múltiples focos irregulares de tonalidad blanquecina en el subendo cardio ventricular (Figura 3).

Figura 2 Glándula adrenal (Corte transversal): Nodulación bien delimitada de color amarillo ubicada en la médula.

Figura 3 Corazón (vasos coronarios): Se observan los vasos arteriales coronarios severamente engrosados e irregulares, con depósito de material amarillo en la pared.
El encéfalo mostró congestión en leptomeninges, en la región ventral las arterias basilares, del laberinto, cerebral caudal y rostral, cerebral media y del círculo arterial tuvieron características similares a las coronarias. En el estómago además de cianosis, edema de la mucosa y erosiones superficiales, los vasos arteriales de la serosa tenían cambios similares a los antes descritos.
Lesiones microscópicas
La tiroides mostró una severa atrofia folicular generalizada, folículos reducidos de tamaño e irregulares, la mayoría perdieron el coloide o permanecieron con escaso coloide condensado, áreas de infiltración de tejido adiposo en el intersticio (Figuras 4 y 5), múltiples focos de infiltrado de linfocitos y células plasmáticas, con predominio de los primeros, cambios ateroscleróticos en vasos arteriolares.

Figura 4 Tiroides. Se observa infiltración moderada de tejido adiposo entre los lobulillos, además de focos de inflamación linfoplasmocitaria (40X, H&E).

Figura 5 Tiroides: Inflamación difusa de tipo linfoplasmocitario y severa atrofia de folículos, los cuales carecen de coloide en el lumen (200X, H&E).
En las arterias coronarias se formaron múltiples placas ateromatosas con depósito de cristales de colesterol y adipocitos en la adventicia, también se observaron focos de mineralización e infiltrado de macrófagos espumosos, focos de hemorragia en la pared y pigmentos fagocitados, fibrosis periférica, y particularmente formación de trombos luminares con cambios endoteliales; por su parte el miocardio mostró necrosis isquémicas multifocales agudas y crónicas, acompañadas de proliferación de tejido conectivo (Figura 6). En la glándula adrenal se observó crecimiento neoplásico de médula, con organización a manera de pseudoacinos delimitados incompletamente por tabiques delgados de tejido conectivo con crecimiento expansivo; las células de morfología redonda o poligonal, de citoplasma basofílico granular, con pleomorfismo celular y anisocitosis leves, núcleos redondos, con pleomorfismo nuclear y anisocariosis leves, compatible con feocromocitoma. Las arterias de páncreas, riñón, cerebro, serosa gástrica y bazo igualmente fueron afectadas por ateroesclerosis severa multifocal; este último, además sufrió depleción linfoidea severa mixta. En la piel había ortoqueratosis severa, fragmentación de la queratina, en focos queratina en cesto, la epidermis con atrofia severa en ocasiones hasta una sola capa celular, la dermis mostró desorganización severa y fragmentación del colágeno, disminución severa de la población de anexos, y los folículos pilosos con tendencia a ubicarse superficialmente llenos de queratina y con atrofia severa del epitelio folicular.
Discusión
La historia clínica, el perfil de hormonas tiroideas, el perfil lipídico, hallazgos a la necropsia e histopatología, permitieron emitir el diagnóstico de hipotiroidismo primario, se propone que sea de origen autoinmune debido a la evidencia de infiltración linfoplasmocitaria, la cual no es común (o es mínima) en los casos de atrofia idiopática 7,10, para este caso se propone que la atrofia tiroidea sería una manifestación crónica de una tiroiditis inicial 4,11.
Aunque existen ciertas similitudes entre las tiroiditis linfocíticas de los humanos y de los caninos 7, el presente caso tiene ciertas particularidades que permiten clasificarlo como una tiroiditis no-Hashimoto, entre estas se destaca, la ausencia de bocio 6,16; adicionalmente, en la tiroiditis de Hashimoto, aparte de la infiltración extensa de linfocitos, es bastante común y notoria la formación de centros germinales y el cambio oncocítico epitelial, lo cual no se encontró en este caso; por ende la recomendación actual es no usar como sinónimos los términos tiroiditis linfocítica y tiroiditis de Hashimoto16.
La base inmune para el desarrollo de la tiroiditis linfocítica crónica tanto en humanos como en caninos es a través de la producción de autoanticuerpos contra la tiroglobulina y la tiroperoxidasa principalmente, se reportan otros autoantígenos, pero son menos frecuentes 2,4,10. En este caso no fue posible realizar la detección de autoanticuerpos debido a que dicha técnica no está disponible en el país. Sin embargo, sí se hizo la caracterización molecular de los linfocitos dentro del tejido tiroideo, la cual fue positiva solamente para linfocitos T; aunque no se conoce el comportamiento cronológico de los linfocitos dentro del órgano, se sabe que la fase inflamatoria (tiroiditis linfocítica) progresa a una fase atrófica caracterizada entre otras por el reemplazo de tejido glandular por tejido adiposo y fibroso, en donde los niveles circulantes de autoanticuerpos desaparecen 4,11; en nuestra opinión, los linfocitos B serían los primeros en desaparecer, mientras que los linfocitos T perdurarían mayor tiempo en el tejido, en cuyo caso la lesión glandular se atribuiría en este punto al efecto de linfocitos T autoreactivos helper y citotóxicos 17 en términos de perpetuación de la tiroiditis linfocítica 10.
El hipotiroidismo cursa con signos clínicos complejos, debido al efecto de la deficiencia de la hormona en múltiples sistemas del cuerpo 18. Dada la importancia de las hormonas tiroideas en la función del sistema nervioso, se observan alteraciones a nivel central y periférico. La disminución en el consumo de glucosa provoca letargia y somnolencia (4, lo que en parte puede explicar la disminución de la actividad y la depresión en el presente caso. Adicionalmente, en el hipotiroidismo existe una disminución de la tasa metabólica basal, lo cual lleva a obesidad, ganancia de peso e intolerancia al ejercicio 7,18, lo cual explicaría la condición corporal del animal.
Los sincopes históricos reportados se pueden explicar por los múltiples infartos agudos y crónicos del miocardio. Los infartos en este caso son lesiones de tipo isquémico a causa de la oclusión arterial consecuencia de la aterosclerosis coronaria severa, esta es favorecida por la alteración sistémica en el metabolismo de lípidos debido a la inadecuada concentración de hormonas tiroideas, la cual lleva a deficiente conversión del colesterol a ácidos biliares u otras sustancias y su posterior eliminación intestinal; de igual manera no se incrementan los niveles de receptores LDL y de las enzimas involucradas en el metabolismo de las lipoproteínas y el transporte reverso de colesterol, tales como la lipasa hepática y la lipoproteína lipasa; así mismo se reduce la sensibilidad del tejido adiposo a la lipolisis 19,20,21,22; por lo anterior, se ha establecido que el hipotiroidismo es un factor de riesgo para el desarrollo de aterosclerosis y consecuentes infartos en el miocardio 23,24, como sería lo ocurrido en este caso. En adición, existen cambios funcionales reportados en los casos de hipotiroidismo que se presentan incluso desde las formas subclínicas, entre ellos están el incremento de la resistencia vascular sistémica, rigidez arterial central, disfunción endotelial, hemostática y plaquetaria (21, lo cual en el presente caso hubiese favorecido un estado protrombótico, que en concomitancia con la hiperlipidemia serían determinantes en la progresión de la aterosclerosis 23,24.
A pesar de que uno de los hallazgos clínicos comunes en perros hipotiroideos es la bradicardia 10 en este caso particular se evidenció taquicardia. La taquicardia se explicaría principalmente por el estímulo simpático sobre el corazón que tendrían los productos secretados por la médula adrenal en su estado neoplásico, la médula adrenal secreta epinefrina y norepinefrina estimulando receptores adrenérgicos 25; estas sustancias estimulan los receptores beta-adrenérgicos en el miocardio generando un efecto inotrópico y cronotrópico sobre la contracción miocárdica 19, particularmente sensible es el nodo sinoatrial, lugar determinante como origen de las taquicardias supraventriculares, por lo cual su sobreestímulo se propone como la causa de dicha taquicardia en el actual caso. Además, las hormonas adrenales se unen a los receptores alfa-adrenérgicos en el músculo liso vascular generando vasoconstricción y consecuente disminución del flujo sanguíneo 25, esto sería determinante en el presente caso y explicaría en parte los infartos en el miocardio.
Las anormalidades dermatológicas se reportan hasta en el 85% de los caninos con hipotiroidismo 26,27,28,29 las mismas son diversas e incluyen entre otras, alopecia, descamación, seborrea, pioderma y resequedad; dichos cambios se explican por la participación de las hormonas tiroideas en el crecimiento y metabolismo tisular cutáneos, en el establecimiento del estrato córneo y la proliferación de queratinocitos y fibroblastos dérmicos. En cuanto al ciclo folicular, las hormonas tiroideas se requieren para la iniciación de la fase anágena 18. En el presente caso las lesiones fueron leves y se limitaron a alopecia abdominal ventral y descamación en la región facial, esta particularidad se atribuyó a que el animal ya había sido tratado por un tiempo con hormonas tiroideas y su deficiencia para las funciones basales dérmicas descritas ya había sido parcialmente cubierta.